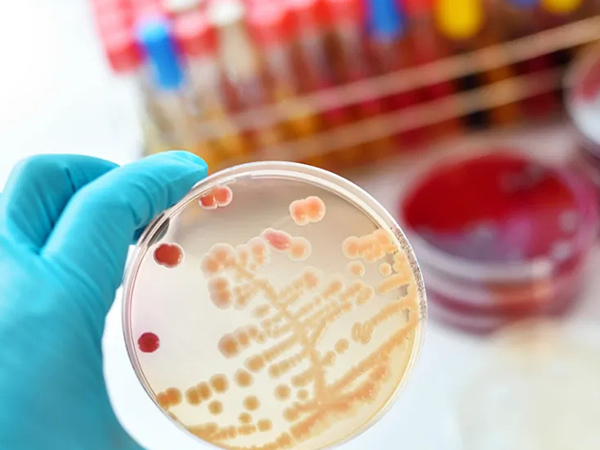

新聞中心
發布日期:2024-03-21點擊:1031
近日,國務院印發《推動大規模設備更新和消費品以舊換新行動方案》,旨在促進各行業的設備升級換代,方案提出,到2027年,工業、農業、建筑、交通、教育、文旅、醫療等領域的設備投資規模相較于2023年將實現25%以上的增長。《行動方案》明確了5方面20項重點任務其中實施設備更新行動第四點提到:提升教育文旅

發布日期:2024-03-18點擊:4521
01OD600的應用--幫助了解細菌的生長狀態OD600是指在600nm波長處的吸光值,常常被用于分析細菌生長和進行抗生素敏感性測試,在細菌檢測中,測量波長需要選擇在生物材料吸光度最小的范圍內。因此,這些細菌生長曲線測量通常使用600-670nm左右的紅色波長。在細菌連續培養過程中,在不同的時間點檢
發布日期:2024-03-16點擊:994
2022年9月7日,國務院總理主持召開常務會議,指出“著力以消費和投資拉需求、促進社會投資、以投資帶消費”,由中央財政支持對九大領域的“設備購置和更新改造新增貸款,實施階段性鼓勵政策”。該貼息貸款政策覆蓋高校、職業院校、醫院、中小微企業等領域的設備購置和更新改造,總體規模為1.7萬億。近日,國家衛健

發布日期:2024-03-11點擊:805

發布日期:2024-03-04點擊:827
肝細胞癌(HCC)是世界上發病率和死亡率最高的腫瘤之一,其發病率和死亡率分別位列第六位和第四位。轉化生長因子-β(TGF-β)作為腫瘤免疫微環境中重要的免疫信號分子,可以和細胞表面的TGF-β受體相結合,激活信號通路,影響腫瘤微環境中腫瘤細胞和免疫細胞功能,在腫瘤的發生發展過程中扮演著重要的角色。在

發布日期:2024-02-26點擊:735
親愛的客戶們、朋友們,今天是正月初九,我們開工了,開門九九九,好運財運到永久,開工大吉!春節假期悄悄地結束了,新的一年,蓄滿能量,鼓起勇氣,繼續奮斗,以更好的精神迎接新一年的工作。揣著節日的喜慶,抱著節日的快樂,挎著節日的溫馨,舉著節日的順心,裝著節日的美好,擁抱節日的祈愿,踏上工作的旅程;打起精神

發布日期:2024-02-04點擊:576
尊敬的各位新老客戶們、親愛的伙伴朋友們:年終歲尾,我們將和2023年揮手說再見,即將迎來的是一個充滿吉祥寓意的2024年——龍年。我們懷著感激之情,向您致以最衷心的祝福。感謝您在過去的一年里對我們的信任與支持,正是有了您的支持,我們才能取得今天的成績。春節期間,結合我司實際情況及國家法定假期安排進行

發布日期:2024-01-27點擊:2162
在《Biacore檢測蛋白與小分子相互作用的常見問題(上)》中我們著重介紹了在實驗設計以及樣品準備方面的問題,在本文的下篇中,我們還是從智薈專線收集的客戶咨詢出發,將繼續討論在實驗進行過程中和最終的數據分析階段可能遇到的常見問題,并逐一揭開上篇中遺留的各個懸念……一、 關于溶劑校正的問題溶劑校正流程

發布日期:2024-01-27點擊:1958
不管是在藥物研發還是基礎科研中,檢測蛋白與小分子的相互作用都是一類重要的實驗。小分子最主要的特點是分子量較小,一般在1000 Da以下;并且結構性質各異,部分溶解度較差,需要使用有機溶劑(例如DMSO等)促溶;這些特點給相互作用的檢測帶來很大的挑戰。基于SPR(表面等離子體共振)原理的Biacore

